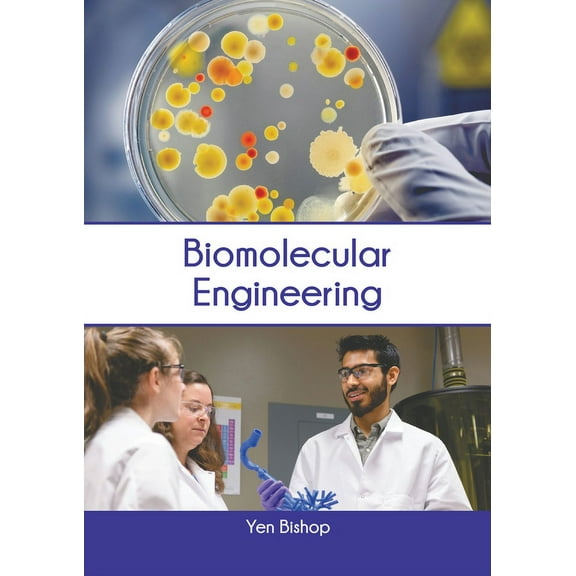
Biomolecular Engineering, (Hardcover)

Pre-Owned BooksAfrican American History BooksAfrican History BooksAfrican Language BooksAges 3-5 Children's BooksAges 3-5 Kids' BooksAges 6-8 Kids' BooksAges 9-12 Kids' BooksAlgebra BooksAlternative & Complementary Medicine BooksAmericas History BooksAncient History BooksAntiques & Collectibles BooksArabic Language BooksArchitecture BooksArt BooksArt Techniques BooksArts & Humanities BooksAsian History BooksBeverage & Wine BooksBibliographies & IndexesBoating BooksBook Printing & Binding Crafts & Hobbies BooksBuddhist Philosophy BooksBusiness & Financial Law BooksBusiness & Money BooksBusiness Writing BooksCalculus BooksCanadian History BooksCeltic Language BooksChristian Books & BiblesCivil Rights Political BooksCivilization History BooksClassic Kids' BooksColonialism & Post-Colonialism Political BooksCommerce Business & Investing BooksComplex Analysis Mathematics BooksComputer & Technology BooksComputers & Engineering BooksCourt Rules BooksCultural Heritage Biographies & MemoirsCzech Language BooksDesign BooksDictionariesDiet & Nutrition BooksDog, Cat & Pet BooksDrama BooksEconomics BooksEducation BooksEncyclopediasEntrepreneurship BooksEssay History BooksEssays on Law BooksEthics & Moral Philosophy BooksEuropean History BooksFamily & Relationships Self-Help BooksFiction NovelsFinance BooksFishing BooksForeign Language Study & Reference BooksForensic Medicine BooksFrench Language BooksGame & Activity BooksGardening BooksGenealogy & Heraldry Reference BooksGeneralGeneral Biographies & MemoirsGeneral Business & Money BooksGeneral Computers & Technology BooksGeneral CookbooksGeneral Crafts & Hobbies BooksGeneral Foreign Language Study & Reference BooksGeneral Kids' BooksGeneral Language Arts & Disciplines BooksGeneral Law BooksGeneral Mathematics BooksGeneral Medical BooksGeneral Political BooksGeneral Reference BooksGeneral Self-Help BooksGeneral Sports BooksGeometry BooksGerman Language BooksGovernment Law BooksHebrew Language BooksHistorical Biographies & MemoirsHistory & Surveys Philosophy BooksHistory BooksHistory of Education BooksHomeopathyHouse & Home BooksHunting BooksIndustries BooksInfectious Diseases BooksInternal Medicine BooksInternational Business & Money BooksInternational Law BooksJournalism BooksLanguage Arts & Disciplines BooksLatin American History BooksLatin Language BooksLaw BooksLibrary & Information Science BooksLinguistics BooksLiterary Biographies & MemoirsLiterary Collection BooksLiterary Criticism BooksLogic Philosophy BooksMagazinesMaritime History & Piracy BooksMarketing BooksMathematical & Statistical Software BooksMathematics BooksMedical BooksMedical History BooksMedical Reference BooksMedieval History BooksMetalwork Crafts & Hobbies BooksMiddle Eastern History BooksMilitary History BooksMiscellaneous Language BooksModern History BooksMoney & Monetary Policy BooksMotivational & Inspirational Self-Help BooksMusic BooksNative American History BooksNature BooksNeuroscience BooksNew Age & Spirituality BooksOceanic & Australian Language BooksOceanic History BooksOpthalmology BooksOrganizations & Educational Institutions BooksPathology BooksPeace Political BooksPerforming Arts BooksPersonal Finance BooksPersonal MemoirsPharmacy BooksPhilosophy BooksPhilosophy, Theory & Social Aspects of Education BooksPhotography BooksPhysical Education BooksPoetry BooksPolitical BooksPolitical History & Theory BooksPolitical Ideology BooksPolitical Philosophy BooksProgramming BooksProgramming Language BooksPsychiatry BooksPsychology BooksPublic Affairs & Administration Political BooksPublic Finance BooksPublic Policy Political BooksReal Estate Business & Money BooksReference BooksReference History BooksReference Law BooksReligion & Religious Studies BooksReligious Philosophy BooksRussian History BooksSales & Selling BooksScience BooksSewing Crafts & Hobbies BooksShop Travel Books, Maps & Guides by InterestShop Travel Books, Maps & Guides by RegionSocial History BooksSocial Science BooksSoftware Development & Engineering BooksSpanish Language BooksSpecific Ingredient CookbooksSpiritual Self-Help BooksStudy Aids & Test Prep BooksStudy Guide BooksSurgery BooksSwedish Language BooksTeaching Methods & MaterialsTechnology & Engineering BooksTransportation BooksUnited States History BooksVector Analysis Mathematics BooksVeterinary Medicine BooksWorld History BooksYearbooks & Annuals
Pre-Owned BooksAfrican American History BooksAfrican History BooksAfrican Language BooksAges 3-5 Children's BooksAges 3-5 Kids' BooksAges 6-8 Kids' BooksAges 9-12 Kids' BooksAlgebra BooksAlternative & Complementary Medicine BooksAmericas History BooksAncient History BooksAntiques & Collectibles BooksArabic Language BooksArchitecture BooksArt BooksArt Techniques BooksArts & Humanities BooksAsian History BooksBeverage & Wine BooksBibliographies & IndexesBoating BooksBook Printing & Binding Crafts & Hobbies BooksBuddhist Philosophy BooksBusiness & Financial Law BooksBusiness & Money BooksBusiness Writing BooksCalculus BooksCanadian History BooksCeltic Language BooksChristian Books & BiblesCivil Rights Political BooksCivilization History BooksClassic Kids' BooksColonialism & Post-Colonialism Political BooksCommerce Business & Investing BooksComplex Analysis Mathematics BooksComputer & Technology BooksComputers & Engineering BooksCourt Rules BooksCultural Heritage Biographies & MemoirsCzech Language BooksDesign BooksDictionariesDiet & Nutrition BooksDog, Cat & Pet BooksDrama BooksEconomics BooksEducation BooksEncyclopediasEntrepreneurship BooksEssay History BooksEssays on Law BooksEthics & Moral Philosophy BooksEuropean History BooksFamily & Relationships Self-Help BooksFiction NovelsFinance BooksFishing BooksForeign Language Study & Reference BooksForensic Medicine BooksFrench Language BooksGame & Activity BooksGardening BooksGenealogy & Heraldry Reference BooksGeneralGeneral Biographies & MemoirsGeneral Business & Money BooksGeneral Computers & Technology BooksGeneral CookbooksGeneral Crafts & Hobbies BooksGeneral Foreign Language Study & Reference BooksGeneral Kids' BooksGeneral Language Arts & Disciplines BooksGeneral Law BooksGeneral Mathematics BooksGeneral Medical BooksGeneral Political BooksGeneral Reference BooksGeneral Self-Help BooksGeneral Sports BooksGeometry BooksGerman Language BooksGovernment Law BooksHebrew Language BooksHistorical Biographies & MemoirsHistory & Surveys Philosophy BooksHistory BooksHistory of Education BooksHomeopathyHouse & Home BooksHunting BooksIndustries BooksInfectious Diseases BooksInternal Medicine BooksInternational Business & Money BooksInternational Law BooksJournalism BooksLanguage Arts & Disciplines BooksLatin American History BooksLatin Language BooksLaw BooksLibrary & Information Science BooksLinguistics BooksLiterary Biographies & MemoirsLiterary Collection BooksLiterary Criticism BooksLogic Philosophy BooksMagazinesMaritime History & Piracy BooksMarketing BooksMathematical & Statistical Software BooksMathematics BooksMedical BooksMedical History BooksMedical Reference BooksMedieval History BooksMetalwork Crafts & Hobbies BooksMiddle Eastern History BooksMilitary History BooksMiscellaneous Language BooksModern History BooksMoney & Monetary Policy BooksMotivational & Inspirational Self-Help BooksMusic BooksNative American History BooksNature BooksNeuroscience BooksNew Age & Spirituality BooksOceanic & Australian Language BooksOceanic History BooksOpthalmology BooksOrganizations & Educational Institutions BooksPathology BooksPeace Political BooksPerforming Arts BooksPersonal Finance BooksPersonal MemoirsPharmacy BooksPhilosophy BooksPhilosophy, Theory & Social Aspects of Education BooksPhotography BooksPhysical Education BooksPoetry BooksPolitical BooksPolitical History & Theory BooksPolitical Ideology BooksPolitical Philosophy BooksProgramming BooksProgramming Language BooksPsychiatry BooksPsychology BooksPublic Affairs & Administration Political BooksPublic Finance BooksPublic Policy Political BooksReal Estate Business & Money BooksReference BooksReference History BooksReference Law BooksReligion & Religious Studies BooksReligious Philosophy BooksRussian History BooksSales & Selling BooksScience BooksSewing Crafts & Hobbies BooksShop Travel Books, Maps & Guides by InterestShop Travel Books, Maps & Guides by RegionSocial History BooksSocial Science BooksSoftware Development & Engineering BooksSpanish Language BooksSpecific Ingredient CookbooksSpiritual Self-Help BooksStudy Aids & Test Prep BooksStudy Guide BooksSurgery BooksSwedish Language BooksTeaching Methods & MaterialsTechnology & Engineering BooksTransportation BooksUnited States History BooksVector Analysis Mathematics BooksVeterinary Medicine BooksWorld History BooksYearbooks & Annuals
Bishop Engineering
Uses item details. Price when purchased online

![History of Delaware County [Pa.] for the Past Century ... Read Before the Delaware County Institute of Science (Paperback)](https://i5.walmartimages.com/seo/History-of-Delaware-County-Pa-for-the-Past-Century-Read-Before-the-Delaware-County-Institute-of-Science-9781016891479_9606f4e0-9446-4b0e-a2ae-405e452b9efc.6fb06ef8fffade6ecc3af82d11e429d4.jpeg?odnHeight=576&odnWidth=576&odnBg=FFFFFF)
![Black, variant on History of Delaware County [Pa.] for the Past Century ... Read Before the Delaware County Institute of Science (Paperback)](https://i5.walmartimages.com/asr/3b725b6a-25b5-4fc4-a00c-ba1218e595fa.8cae63dc71ac7c40a9de2e4e95ac4c98.jpeg?odnHeight=30&odnWidth=30&odnBg=FFFFFF)
![Blue, variant on History of Delaware County [Pa.] for the Past Century ... Read Before the Delaware County Institute of Science (Paperback)](https://i5.walmartimages.com/asr/f01f2189-c7de-49ec-8f38-05ad9f331fbf.6ef55a4bad1ae1cca5f08edd13521234.jpeg?odnHeight=30&odnWidth=30&odnBg=FFFFFF)
![Colorful, variant on History of Delaware County [Pa.] for the Past Century ... Read Before the Delaware County Institute of Science (Paperback)](https://i5.walmartimages.com/asr/62be603c-cc9b-482f-8105-75b7f9ffca9c.a8e24421938668195d2fc8941134e462.jpeg?odnHeight=30&odnWidth=30&odnBg=FFFFFF)
![Gold, variant on History of Delaware County [Pa.] for the Past Century ... Read Before the Delaware County Institute of Science (Paperback)](https://i5.walmartimages.com/asr/2d12fa1a-4203-4ea4-8194-2046016fe87b.d4adc0b1163b280bb89f16f151ee95f4.jpeg?odnHeight=30&odnWidth=30&odnBg=FFFFFF)
















